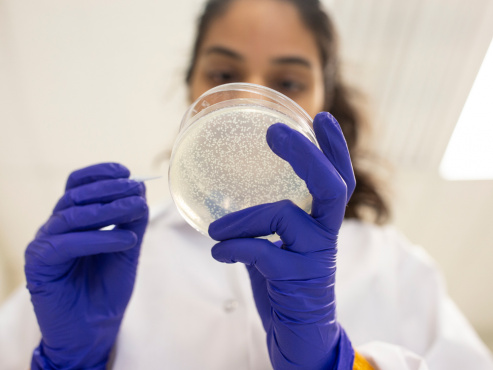
image

Scientists racing to create lab-grown synthetic cannabinoids, but cannabis plant not obsolete just yet
Kevin Chen spent much of the last two years attending every cannabis-related conference he could find, trying to convince investors about the potential of a scientific development he had come up with in his student lab at Concordia University: Using yeast to create cannabinoids such as CBD, a compound now widely used in cannabis-based ingestibles and pharmaceuticals.
A month before legalization, Chen finally struck gold — Organigram Holdings, a New-Brunswick-based licensed producer agreed to invest $10 million in Hyasynth Bio, Chen’s Montreal-based startup.
“We are a lot closer to being able to produce our ingredients in bulk because of the investment,†Chen told the Financial Post in an interview recently. “Two years ago, we just had a frozen vial of yeast cells, but now, our yeast strains are producing many different cannabinoids that we’re hoping to sell on a large scale.â€
- Nations going to pot: Where cannabis is legal around the world, and where it isn’t
- Green Growth Brands signs deal to bring CBD body scrubs and bath bombs to Abercrombie & Fitch
- The much-hyped CBD market in the U.S. may reach $16 billion by 2025
Hyasynth Bio is one of just a few Canadian companies experimenting with non-plant-derived cannabinoids, a sub-sector within the cannabis space that is starting to gain the attention of major investors and industry players.
The concept is relatively simple — instead of extracting cannabinoids from a cannabis plant to be put into oils, drinks, food, medicines and beauty products, compounds like CBD and THC can be created in a lab using either organic hosts like yeast and sugar (to create biosynthetic cannabinoids), or petroleum-based industrial chemicals that mimic the chemical structure of a cannabinoid (synthetic cannabinoids).

Kevin Chen, Hyasynth Bio co-founder and CEO. Christinne Muschi for National Post
“If you think of aspirin, for example, it was originally discovered in the bark of a willow tree. But today, we don’t have forests of willow trees to extract aspirin because it was chemically synthesized many years ago,†explained David Eisley, chief executive of Cardiol Therapeutics Inc., a publicly-listed biotechnology company that manufactures a synthetic CBD drug used for heart failure called Cardiol Rx.
“It is absolutely inevitable that synthetic cannabinoids are going to become a large part of the cannabis industry. History teaches us that to ultimately make any medicine widely accessible to the public, it has to be made pharmaceutically at an affordable cost,†said Eisley.
The demand for pure CBD as an active pharmaceutical ingredient traverses both the recreational and medical cannabis space. Hyasynth Bio, for instance, wants to eventually be able to produce thousands of kilograms of CBD in powder-form using its yeast formula to be sold to major pharmaceutical or consumer-packaged goods companies.
But they’re at least two years away from being able to achieve that level of yield. Chen says his lab is still at an R&D stage, producing a few grams of CBD at most.
It is absolutely inevitable that synthetic cannabinoids are going to become a large part of the cannabis industry
David Eisley, chief executive of Cardiol Therapeutics
In mid-April, Willow Biosciences Inc., a small Calgary-based startup became the first Canadian biosynthetic cannabinoid company to go public. Willow listed on the Canadian Securities Exchange, and raked in $30 million in the process.
“We had been doing synthetic biology formulations from medical plants for a really long time, and we were the first to reach commercial scale with our production of a synthetic opioid pharmaceutical derived from the genome sequence of the poppy plant. So we’ve been in the API (active pharmaceutical ingredient) space for quite some time now,†said Trevor Peters, the company’s CEO.
What Willow is now experimenting with in relation to the cannabis plant is similar to what Hyasynth is doing — manufacturing a variety of cannabinoids in a lab using yeast. But yeast isn’t the friendliest microorganism to deal with, creating a variety of scale-up challenges for Peters and his team.

Daniel Korvin, a scientist at Hyasynth Bio, works with in a batch of fermenting yeast. Christinne Muschi for National Post
“Plants have evolved over time to fight off things like yeast, so the yeast cell tends to spit out what you’re trying to put in it. Where the real yield improvement comes in is when you can come up with a formulation that can fool the yeast into thinking that it is not a plant cell or plant gene that is being put into it,†explained Peters.
He says Willow is about two years away from being able to produce CBD in bulk, but no earlier. “I have seen a lot of forecasts that say companies are going to be ready by the end of 2019, and we’re going to be able to disrupt cannabis cultivation altogether and I think that’s probably a bit aggressive.â€
Regardless, a slew of large licensed producers have already started investing in synthetic and biosynthetic cannabinoid companies.
In early May, Canopy Growth Corp. signed a $343-million deal to buy C3 Cannabinoid Compound, a German company that is the lead distributor of a medicine called dronabinol containing synthetic THC and used as an appetite stimulant and sleep apnea reliever. It was the first synthetic cannabinoid product that German physicians were allowed to prescribe.
In a press release, Canopy’s chief medical officer Dr. Mark Ware characterized the acquisition as a necessary move in order to “change the conversation†around cannabis-based therapeutics.
Cronos Group, meanwhile, has an agreement with Ginkgo Bioworks Inc. to invest in the development of “microorganisms capable of producing certain target cannabinoids in a scalable and highly efficient manner.†Cronos’ investment, however, is subject to Gingko demonstrating that it can indeed produce a certain yield of pure cannabinoids.
“The technology is not there yet to commercialize biosynthetics at scale. But in 18 to 24 months you’ll see a very different landscape, because when you finally master the technology to make cannabinoids in bulk in a lab, you’re looking at a much lower cost overall,†said David Kideckel, managing director and senior equity research analyst at investment firm AltaCorp Capita, which advises cannabis companies.
When you finally master the technology to make cannabinoids in bulk in a lab, you’re looking at a much lower cost overall
David Kideckel, managing director AltaCorp Capita
That does not necessarily mean that it is cheaper to produce THC or CBD in a lab than it is to extract it from a cannabis plant growing outdoors or in a greenhouse. Kideckel estimates that it costs under $1,000 to produce a kilogram of pure CBD or THC in a lab, which is five to eight times what it costs to extract THC and CBD from the plant.
But where he believes the real advantage of biosynthetic technology will be seen is in establishing long-term cost consistency for the production of all cannabinoids, not just THC or CBD.
“There are over 100 cannabinoids in the plant,†Kideckel explains, most of which are too costly to extract. “While THC and CBD can be readily extracted from the plant, it is the rare cannabinoids that you can’t get right now. In a lab, it does not matter what you’re producing, the cost remains the same.â€
But very little research has been done on the lesser-known components of the cannabis plant like cannabigerol (CBG) or cannabichromene (CBC) that it is hard to foresee their potential benefits, let alone demand for them as active pharmaceutical ingredients.

It’s still cheaper to produce THC or CBD from a cannabis plant. Pablo Porciuncula Brune/AFP/Getty Images
“I agree that the market is not ready for cannabinoids besides THC and CBD. But as soon as cannabis is descheduled as a controlled substance on a federal level in the United States, you’re going to start seeing research dollars pouring in from Big Pharma and CPG companies. They’re going to work on figuring out the potential of every cannabinoid in the plant,†Kideckel said.
In the meantime, it is licensed producers and extraction companies like Valens GroWorks and MediPharm Labs that are filling the demand for cannabinoids as an active ingredient in the lead up to Canada legalizing cannabis ingestibles, concentrates and topicals later this year.
For cannabis purists, the idea of manufacturing marijuana in a lab is an affront to the entire culture of cannabis consumption.
“I don’t think you can say synthetic cannabinoids are going to disrupt the cannabis cultivators, there will always, always be demand for flower, for people wanting to smell it and smoke it,†Igor Gimelshtein, president of Zola Global, a family office focusing on the cannabis industry, told a conference in Toronto recently.
Hyasynth’s Chen agrees with that assessment although he points out that if and when cannabinoids begin to have large-scale applications in every aspect of our lives, the idea of growing plants in a sterile way to use as ingredients in products does not make much sense.
“There are of course people who want to smoke weed. But if there’s a product that is going to be in every bathroom and kitchen cabinet because it is the next best thing for migraine, then you’re going to want to make it the same way you make aspirin.â€
• Email: [email protected] | Twitter: VanmalaS